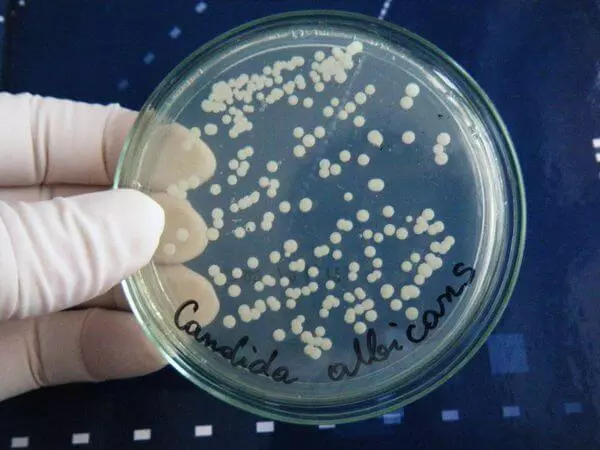

Знаете ли вы, кто такие кандиды? Нет? А ведь они – жители вашей ротовой полости, которые иногда могут вызывать очень «приставучее» заболевание. Название ему – кандидоз полости рта, или молочница. О неприятном соседстве, кандидозе и мерах его профилактики вы узнаете из этой статьи.
- Как выглядит кандидоз полости рта, и кого он поражает?
- Дети
- Беременные женщины
- Пожилые люди
- Другие категории
- «Безобидная молочница»: лечить или нет?
- Осложнения кандидоза
- Острый кандидоз
- Хронический кандидоз
- Как защититься от молочницы
- Грудным детям
- Больным сахарным диабетом
- Проходящим курс лечения антибиотиками
- Пожилым людям
- Общие рекомендации для всех
- 🎬 Видео
Видео:Кандидоз полости ртаСкачать

Как выглядит кандидоз полости рта, и кого он поражает?
Кандидоз – заболевание, которое вызывают грибки рода Candida. Для здоровых людей они безопасны и являются частью нормальной микрофлоры. Но стоит иммунитету ослабнуть, как эти дрожжеподобные организмы дают о себе знать. На слизистых оболочках, в частности, во рту, появляется белый налет, который напоминает скисшее молоко.
За это кандидоз и получил в народе второе имя – молочница. Это явление может сопровождаться зудом, жжением, повышенной чувствительностью слизистой.
Итак, кто наиболее подвержен опасности заболеть кандидозом?
Дети
Да, чаще всего кандидоз полости рта, или кандидозный стоматит, поражает детей до года. Более других страдают от этой напасти недоношенные дети и малыши с дефицитом массы тела.
Причина – в слабой иммунной защите новорожденных. Кроме того, грудное молоко и смеси имеют сладкий вкус, а это способствует быстрому росту грибка.
Обратите внимание: если у ребенка диагностирован кандидоз, уделите особое внимание гигиене его личных средств (посуда, пустышки, бутылки). Мойте грудь с мылом после каждого кормления.
Беременные женщины
Не случайно именно они – вторые в группе риска. Гормональная перестройка делает будущих мам более уязвимыми к появлению молочницы. Однако, обнаружив грибок, паниковать не стоит. В этом случае возможно местное лечение заболевания, которое не нанесет вреда плоду.
Пожилые люди
Помимо ослабленного иммунитета, кандидоз у них провоцируют стоматологические конструкции (мосты, протезы, коронки и т.п.). Недостаточная гигиена полости рта является благодатной средой для развития микроорганизмов.
Другие категории
Иногда кандидозный стоматит встречается и у людей, не относящихся к упомянутым категориям. Это может быть связано с временным расшатыванием защитных систем организма. Тому способствуют стрессы, гормональные сбои, вредные привычки и иногда – принятие оральных контрацептивов.
Кандидоз полости рта может развиться на фоне болезней иммунной и эндокринной системы (сахарного диабета), инфекционных и стоматологических заболеваний, нарушения обменных процессов, лечения антибиотиками.
Видео:Кандидоз полости рта после орального сексаСкачать

«Безобидная молочница»: лечить или нет?
Когда дело касается маленьких детей, у которых во рту замечен белый налет, родители тут же идут к специалисту. Оно и понятно: кандидоз у малышей развивается стремительно. Ребенок плохо себя чувствует, отказывается от еды, капризничает. Да и вообще, здоровье детей – это святое.
А вот взрослые не всегда спешат обратиться к стоматологу. Больших беспокойств на ранних стадиях кандидоз не причиняет. Поэтому, прочитав в Интернете пару полезных статей, люди распознают болезнь и начинают лечить ее народными средствами.
Часто самолечение действительно помогает снять видимые симптомы молочницы. Белый налет исчезает, больной успокаивается. Но спустя несколько дней картина повторяется.
Почему? Потому, что Candida – очень живучий грибок. Чтобы действительно избавиться от него, исцеляющих полосканий недостаточно. Нужен комплексный подход, который включает:
· медикаментозную терапию;
· дополнительные средства (отвары, растворы и т.п.);
· иммуномодулирующую терапию;
· диету.
Причем последний компонент крайне важен. При кандидозе нельзя есть мучное, сладкое, молочные продукты, а также следует исключить алкоголь. Такая пища активизирует рост грибка.
Обратите внимание: применение народных средств может «смазать» клиническую картину и осложнить правильную диагностику. Не стоит также пытаться избавиться от налета механически (удалить ногтем или другим способом). На его месте останутся микротравмы, и риск инфицирования слизистой повысится.
Лечение кандидоза может быть местным и общим. Местное включает применение только средств локального действия на пораженные участки (мази, полоскания, физиотерапия). Общее лечение направлено еще и на укрепление иммунитета (витамины и другие средства).
В целом, молочница хорошо поддается лечению. Но очень важно, чтобы оно было компетентным, ведь Candida умеет «прятаться» в самых труднодоступных местах ротовой полости. Врачи об этом прекрасно знают – поэтому, во избежание осложнений, обратитесь за квалифицированной помощью.
Видео:Кандидозные инфекции - кратко причины, симптомы, диагностика, лечениеСкачать

Осложнения кандидоза

А что же будет, если все-таки вера в силы народной медицины окажется сильнее здравого смысла? В этом случае живучие грибки будут размножаться и завоевывать все больше территории. В конечном итоге молочница может переродиться в острую или хроническую форму.
Острый кандидоз
Он бывает двух видов: псевдомембранозный и атрофический.
1. Псевдомембранозный вариант характеризуется распространением белого налета по всей полости рта, включая нёбо, глотку, пищевод. Болезнь в этой форме причиняет существенный дискомфорт. Наблюдается зуд, отечность и чувствительность слизистых, боль при приеме пищи. Под налетом – кровоточащие эрозии.
2. При атрофической острой форме симптомы усиливаются, возникает сухость во рту. Грибковый налет на этой стадии уже не наблюдается. Вся слизистая воспаляется и становится очень чувствительной.
Хронический кандидоз
Также делится на два вида:
1. При гиперпластическом типе (или кандидозной лейкоплакии) на языке и щеках образуются белые бляшки. Они имеют неровные края и уже не снимаются, как на начальной стадии. Больной ощущает сильную сухость во рту, боль. Язык становится шероховатым.
2. Атрофическая форма хронического кандидоза связана с постоянной травматизацией слизистой, вызванной неправильной установкой протеза или других конструкций. При этой форме в месте установки возникает покраснение. Язык становится гладким (происходит атрофия сосочков). Субъективные ощущения больного – боль, сухость, жжение в пораженном месте.
Видео:Молочница во рту или кандидоз. Клинический случай №107Скачать

Как защититься от молочницы

Грудным детям
Чтобы грудничок не подхватил инфекцию, его маме нужно в первую очередь соблюдать правила гигиены: следить за чистотой рук, груди, игрушек, сосок, посуды и так далее. Если это заболевание выявлено у беременной женщины, ее долг – вылечиться как можно быстрее, дабы болезнь не передалась малышу. Важно ухаживать за полостью рта ребенка и, как только появились первые зубки, начинать их чистить (предварительно ознакомившись с тем, как это правильно делать).
Больным сахарным диабетом
Следите за соблюдением диеты, гигиеной полости рта и старайтесь избегать сухости во рту. Это провоцирует развитие патогенной микрофлоры.
Если ксеростомия (синдром сухости) имеет место, проконсультируйтесь с врачом. Существуют специальные увлажнители для полости рта. Кстати, сухость вызывает и курение, поэтому лучше отказаться от этой привычки.
Проходящим курс лечения антибиотиками
Часто употребление лекарственных средств этой фармакологической группы ведет к дисбалансу микрофлоры. Чтобы предотвратить кандидоз полости рта, рекомендуем принимать специальные препараты от дисбактериоза. Можно также употреблять несладкие кисломолочные продукты. Они содержат полезные бактерии и тоже помогают восстановить нарушенный баланс.
Пожилым людям

Рекомендуем сдавать съемные протезы на профессиональную чистку раз в полгода и постоянно следить за герметичностью несъемных конструкций, т.е. проходить профилактический осмотр.
Если есть запах изо рта или сухость, следует рассказать об этом специалисту. Эти проблемы возможно устранить, снизив риск заболеть кандидозом.
Общие рекомендации для всех
Обязательно проходите профилактические осмотры, не злоупотребляйте высокоуглеводной пищей и поддерживайте иммунную систему.
Если же случилось так, что вы обнаружили у себя признаки кандидоза, обращайтесь к специалистам, они проведут диагностику и назначат лечение, которое поможет вам избавиться от проблемы.
🎬 Видео
Примените эти 6 средств, и кандидоз никогда не вернется👍Скачать

Кандидоз полости рта. Виды, причины, лечение.Скачать

Кандидоз полости ртаСкачать

Молочница: кандидоз полости рта. Как лечить?Скачать

Покраснение вокруг рта и кандидозСкачать

Простые тесты на кандидоз в домашних условияхСкачать

👅 Белый язык при хроническом кандидозе. Клинический случай №864Скачать

Эти простые советы избавят от кандидоза навсегда. Сделай это и кандида покинет организм #здоровьеСкачать

Быстрое Лечение Кандидоза во Рту у ребенка и взрослых. Лечение молочницы ротовой полостиСкачать

857 Кандидоз полости ртаСкачать

🔴 КАНДИДОЗ - ПРИЗНАКИ И ЛЕЧЕНИЕ 🔴 РЕЦЕПТЫ ЗДОРОВЬЯ БЕЗ ЛЕКАРСТВСкачать

Кандидоз у мужчин и женщин?Как лечить? Дерматолог клиники ЦелительСкачать

? Кандидоз - как вылечить?Скачать

Кандидоз слизистой полости рта у людей с сахарным диабетомСкачать

СТОМАТИТ, кандидоз, ЯЗВЫ во рту, пародонтит, пародонтоз: 2 простых средства от этих болезней.Скачать

Кандидоз полости рта: симптомы, лечение, причиныСкачать








